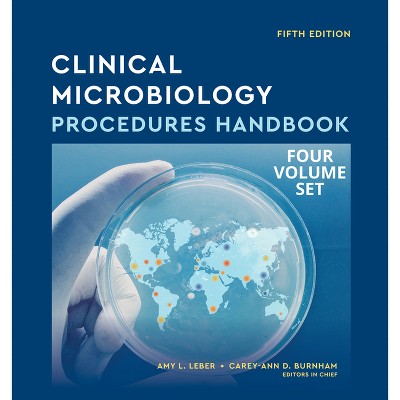

The Drugs Handbook 1985-86 - 5th Edition by Paul Turner & Glyn N Volans Paperback
$51.99Save $3.00 (5% off)
In Stock
Eligible for registries and wish lists
About this item
Additional product information and recommendations
Related Categories
Trending Non-Fiction